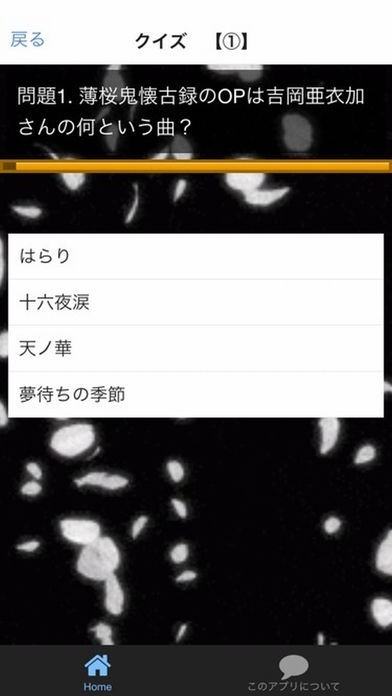

現在、このアプリは配信されていません。
ファン検定 for 薄桜鬼 〜新選組奇譚〜のスクリーンショット
App Storeより引用

「ファン検定 for 薄桜鬼 〜新選組奇譚〜」スペック・仕様
- 開発者
- koji kuma
- リリース
- 2015年12月19日
- サイズ
- 55.36 MB
- 評価
- 3 / 5
- 価格
- 無料
- ダウンロード
ファン検定 for 薄桜鬼 〜新選組奇譚〜の順位推移表
順位推移表が見つかりません
オフィシャル・公式情報
App Storeより引用人気アニメの薄桜鬼からクイズを出題していきます。
制限時間は30秒!全問正解を目指しましょう!
『薄桜鬼 〜新選組奇譚〜』(はくおうき しんせんぐみきたん)は、2008年9月18日にアイディアファクトリー(オトメイト)から発売された女性向け恋愛アドベンチャーゲーム、およびこれを原作とするテレビアニメ、OVA、舞台、ミュージカル、映画。
キャラクターデザイン、原画はカズキヨネが担当。作中には幕末の史実要素も多く取り入れられているが、奇譚とされる一番の特徴として本作の独自要素が中心に描かれることもあり、史実とは異なった展開も多岐に渡る。幕末重要人物のうち、下記で紹介する以外は名前のみの登場となっている。なお、シリーズの中で黎明録のみ、恋愛アドベンチャーではなく歴史アドベンチャーのカテゴリに分類されている。
幕末、文久三年から物語は始まる。主人公・雪村千鶴は江戸育ちの蘭学医の娘。父・綱道は京で仕事をしており離れて生活をしていた。ある日、父との連絡が取れなくなり心配になった千鶴は、男装をして京の町を訪れる。そこで千鶴はある衝撃的な場面に遭遇し、新選組と出会い、父の行方を共に捜すこととなる。新選組隊士達の間で起こる出来事、自身の出生、交わる新撰組の隠された秘密。幕末を駆け抜ける男達の生きるための闘いが繰り広げられる。
